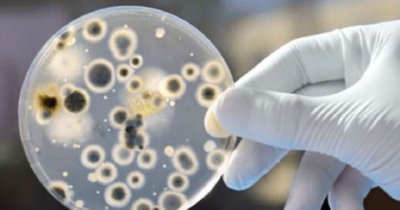

Συναγερμός σήμανε στο νοσοκομείο Ρεθύμνου, καθώς ο μύκητας Candida Auris προσέλαβε 70χρονο ασθενή που νοσηλεύεται σε ΜΕΘ.
Ο ασθενής εξακολουθεί να νοσηλεύεται και είναι καλά στην υγεία του.
Στον ασθενή, όπως ανέφερε στην ΕΡΤ Χανίων ο διευθυντής ΜΕΘ του νοσοκομείου, Χ. Μαρκάκης, χορηγήθηκε αμέσως συγκεκριμένη αγωγή και πλέον η υγεία του εξελίσσεται χωρίς προβλήματα.
Όπως εξήγησε ο κ. Μαρκάκης, μόλις εντοπίστηκε το εν λόγω στέλεχος μετά από καλλιέργεια υπήρξε μεγάλη ανησυχία, όμως την επόμενη μέρα που βγήκε το αντιβιόγραμμα οι γιατροί διαπίστωσαν πως ο μύκητας δεν ήταν πανανθεκτικός, αλλά είχε ευαισθησίες σε αρκετά αντιμυκητιασικά φάρμακα και έτσι, χορηγήθηκε συγκεκριμένη αγωγή στον ασθενή, ο οποίος στη συνέχεια αποστειρώθηκε και πλέον η υγεία του εξελίσσεται χωρίς προβλήματα.
Πρόσθεσε ότι υπάρχουν άλλα στελέχη που είναι πανανθεκτικά και είναι πολύ δύσκολο να αντιμετωπιστούν, ενώ δεν απέκλεισε το ενδεχόμενο στο μέλλον ο μύκητας candida auris να εμφανιστεί ως πανανθεκτικός, κάτι που δεν θεωρεί πολύ πιθανό τώρα με την ύφεση της πανδημίας.
Σημείωσε δε, πως δεν άλλαξε κάτι στο νοσοκομείο Ρεθύμνου και συνεχίζουν να ακολουθούνται οι ενέργειες αποστείρωσης και πρόληψης στη ΜΕΘ, όπως και πριν.
www.bankingnews.gr

Σχόλια αναγνωστών